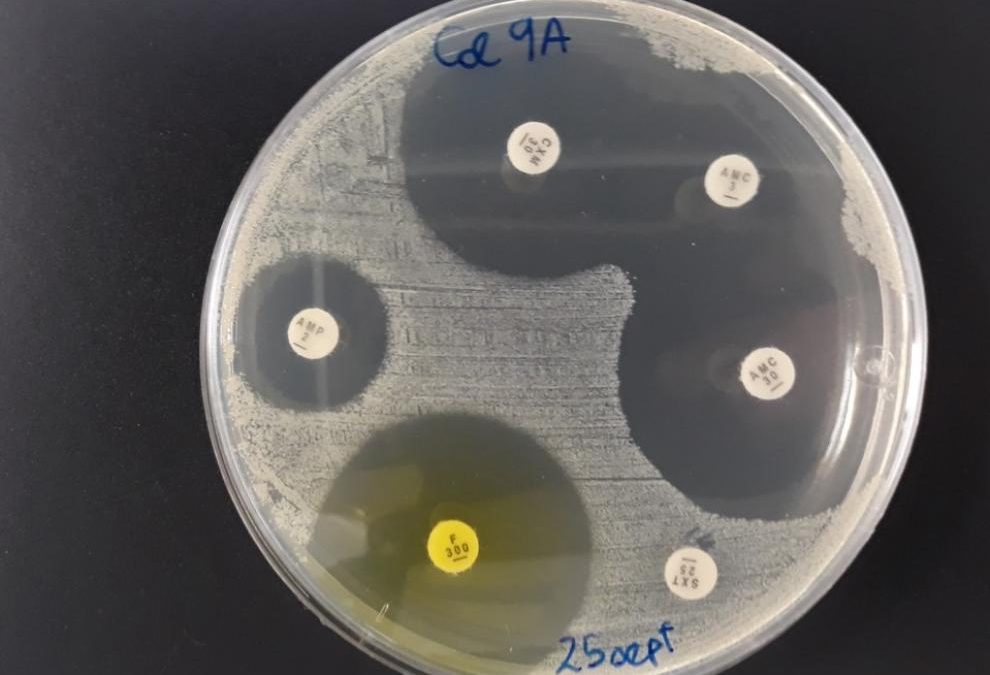

Resistencia bacteriana a los antibióticos, la epidemia silenciosa

Marilourdes de Torres: «Los menús de hospital son una combinación entre ciencia e imaginación»
1 febrero, 2022
Parosmia: cuando lo que olía bien ahora huele fatal
2 febrero, 2022El CITA ha analizado el consumo de antibióticos en 29 explotaciones porcinas de Aragón y Cataluña, así como las resistencias a antibióticos de cuatro bacterias procedentes de los animales en producción. Al dejarnos sin tratamientos eficaces, esta es una de las más serias amenazas para la salud pública.
Cada año, las infecciones causadas por bacterias resistentes a los antibióticos provocan la muerte de 33.000 personas en la UE (unas 3.000 en España). Casi cien años después del descubrimiento de la penicilina, un uso excesivo e inadecuado de estos fármacos está haciendo retroceder su eficacia y cada día son más las bacterias resistentes, hasta el punto que la OMS considera la resistencia a antibióticos una de las principales amenazas para la salud global.
El abuso en la administración de antibióticos se da entre las personas y también en los animales, cuya salud está entrelazada con la salud humana y la salud ambiental en una única ‘One Health’.
Investigadores del Centro de Investigación y Tecnología Agroalimentaria de Aragón (CITA) están siguiendo la pista de estas bacterias multirresistentes en el marco de un proyecto más amplio, financiado por la Agencia Estatal de Investigación, sobre resistencia microbiana a los antibióticos en producción ganadera intensiva. Entre el CREsA de Cataluña, las universidades de Murcia y León y el CITA, han estudiado el porcino, conejos, rumiantes y gallinas.
El Plan de Resistencias a Antimicrobianos controla estas cuatro bacterias marcadoras de antibiorresistencias en alimentos y este estudio del CITA ha demostrado que "ese mismo control puede hacerse también en los animales vivos, obteniendo los mismos resultados antes", señala Clara Marín, investigadora responsable del estudio.
Concretamente, se ha medido la resistencia a 14 antibióticos para E. coli y Salmonella; 12 para Enterococcos spp. y 6 para Campylobacter, y Marín indica que "se apreciaron bacterias multirresistentes en los cuatro grupos bacterianos estudiados".
Este problema surge por administrar antibióticos indiscriminadamente: "Si se dan antibióticos sin haber sido prescritos, pueden aparecer resistencias a los antibióticos cuando surgen infecciones que producen patología (bien humana o animal), que puede ser causada por estas cuatro bacterias que aparecen en el estudio o por otras". Desde hace dos años, "es obligatoria la receta veterinaria para administrar antibióticos a los animales y por eso también ha bajado su uso en España", aunque sigue entre los países de mayor consumo en animales.
Expone claramente que "tenemos que concienciarnos de que los antibióticos los tenemos que tomar –personas y animales– ‘por prescripción’. Tanto los médicos como los veterinarios conocemos que solo se emplean frente a infecciones bacterianas y son inútiles frente a infecciones víricas (como la gripe), por lo que no se deben usar en esos casos". Además, "los tratamientos antibióticos deben ser supervisados, emplear el fármaco indicado y solo durante el tiempo necesario para curar la infección".
En su opinión, el abuso de antibióticos veterinarios va más ligado a la mala praxis que al tipo de explotación. "Se usan más antibióticos en la granja de un ganadero que no actúa como debe: que no llama al veterinario cuando los animales enferman, que no hace un buen diagnóstico de las enfermedades que sufren, que no tiene las instalaciones limpias y acondicionadas para que los animales estén bien alojados y no sufran estrés", enumera Marín.
Normalmente, prosigue, "en las producciones en intensivo, si no se vigila el bienestar animal y se controlan las medidas de bioseguridad en las explotaciones, los animales pueden sufrir estrés. Los animales que se estresan sufren más patologías y estas son las que se tratan". Por eso se dice que "para reducir el uso de antibióticos conviene implementar e incidir en medidas de bienestar animal y de bioseguridad que reduzcan cualquier estrés que el animal pueda sufrir tanto en ganaderías intensivas como extensivas".
En cifras
- La European Food Safety Authority señala a la campylobacteriosis (con 220.682 casos en 2019), la salmonelosis (87.923 casos) y las infecciones por E. coli (7.775) como las tres principales zoonosis en humanos en Europa.
- Aunque en los últimos años se ha reducido significativamente, el uso de antibióticos veterinarios en Europa es muy elevado y, según la European Medicines Agency, España está entre los países de mayor consumo. En 2014, España utilizó 100 veces más por unidad que otros países como Noruega.
- El Plan de Resistencias a Antimicrobianos ha puesto en marcha programas para la reducción voluntaria del consumo de determinados antibióticos en diferentes especies.
Genes de resistencia que pasan de unas bacterias a otras
El ser humano y los animales compartimos el mismo microbioma, es decir, "somos capaces de pasarnos de unos a otros las bacterias, bien compartiendo el espacio (por el aire), bien por contacto directo (tocándonos), bien por los alimentos", describe Clara Marín. Además, "las bacterias son capaces de compartir los genes de resistencia a los antibióticos de unas a otras y mantener en el tiempo la resistencia adquirida". Por eso este fenómeno se ha ganado el nombre de la epidemia silenciosa.
La investigadora del Departamento de Ciencia Animal del CITA explica que "las bacterias ‘saprofitas’, las que tenemos todos y no producen enfermedad, son capaces de coger genes de resistencia a antibióticos y compartirlos con otras bacterias que, en un momento dado, por ejemplo una intervención quirúrgica, una piedra en la vesícula, un traumatismo..., nos produzcan una patología que sea muy difícil de eliminar porque la bacteria que la origina es resistente a muchos antibióticos. Como en las típicas cistitis persistentes por E. coli".
El estudio del CITA siguió la pista a las cuatro bacterias marcadoras de la antibiorresistencia según la normativa europea. Y encontraron que más de la mitad de las E. coli porcinas analizadas eran multirresistentes a cinco antibióticos; para Enterococcos, se constató resistencia a tres antibióticos en más del 50% de los casos; en Salmonella, a tres antibióticos en más del 50%; mientras que para Campylobacter coli de origen porcino se detectaron resistencias a cinco de los seis antibióticos analizados en más del 70% de las bacterias aisladas de los animales de las granjas.
Otra de las conclusiones de este estudio es que "cuando se generan resistencias por el mal uso de antibióticos, no se eliminan de un día para otro", asegura. Así, se analizó la resistencia a la Colistina, antibiótico prohibido en los cerdos desde hacía dos años cuando se hizo el estudio, y aún seguían apareciendo resistencias en E. coli y Salmonella. Lo que indica que "la resistencia a los antibióticos adquirida por las bacterias no se elimina rápidamente tras dejar de administrar el antibiótico, para lograrlo deberá pasar un tiempo de uso racional de estos fármacos".
Alternativas
El estudio del CITA se titula ‘Reducción del uso de antibióticos en producción ganadera intensiva: programa integral de manejo y aplicación de productos alternativos’. ¿Qué otras opciones hay? Para empezar, "tratando con antibióticos solo los animales que lo requieran y siempre haciendo los tratamientos correctamente (antibiótico apropiado y el tiempo recomendado)", aconseja Clara Marín. Ahora, añade, "se promulga también el empleo de prebióticos y probióticos (microorganismos saprofitos) que favorecen el microbioma en distintos nichos ecológicos (mama, digestivo, respiratorio) para prevenir enfermedades".
Asimismo, "se están ensayando continuamente extractos vegetales como aditivos alimenticios que favorezcan la digestión y prevengan diarreas causadas por bacterias".
También se está probando el uso de bacteriófagos (virus específicos que matan bacterias) para eliminar infecciones y "parece que se han obtenido resultados muy prometedores –señala Marín– en infecciones mamarias tanto humanas como en vacas y ya se está ensayando cómo prevenir diarreas en pollos".
Fuente: Heraldo de Aragón